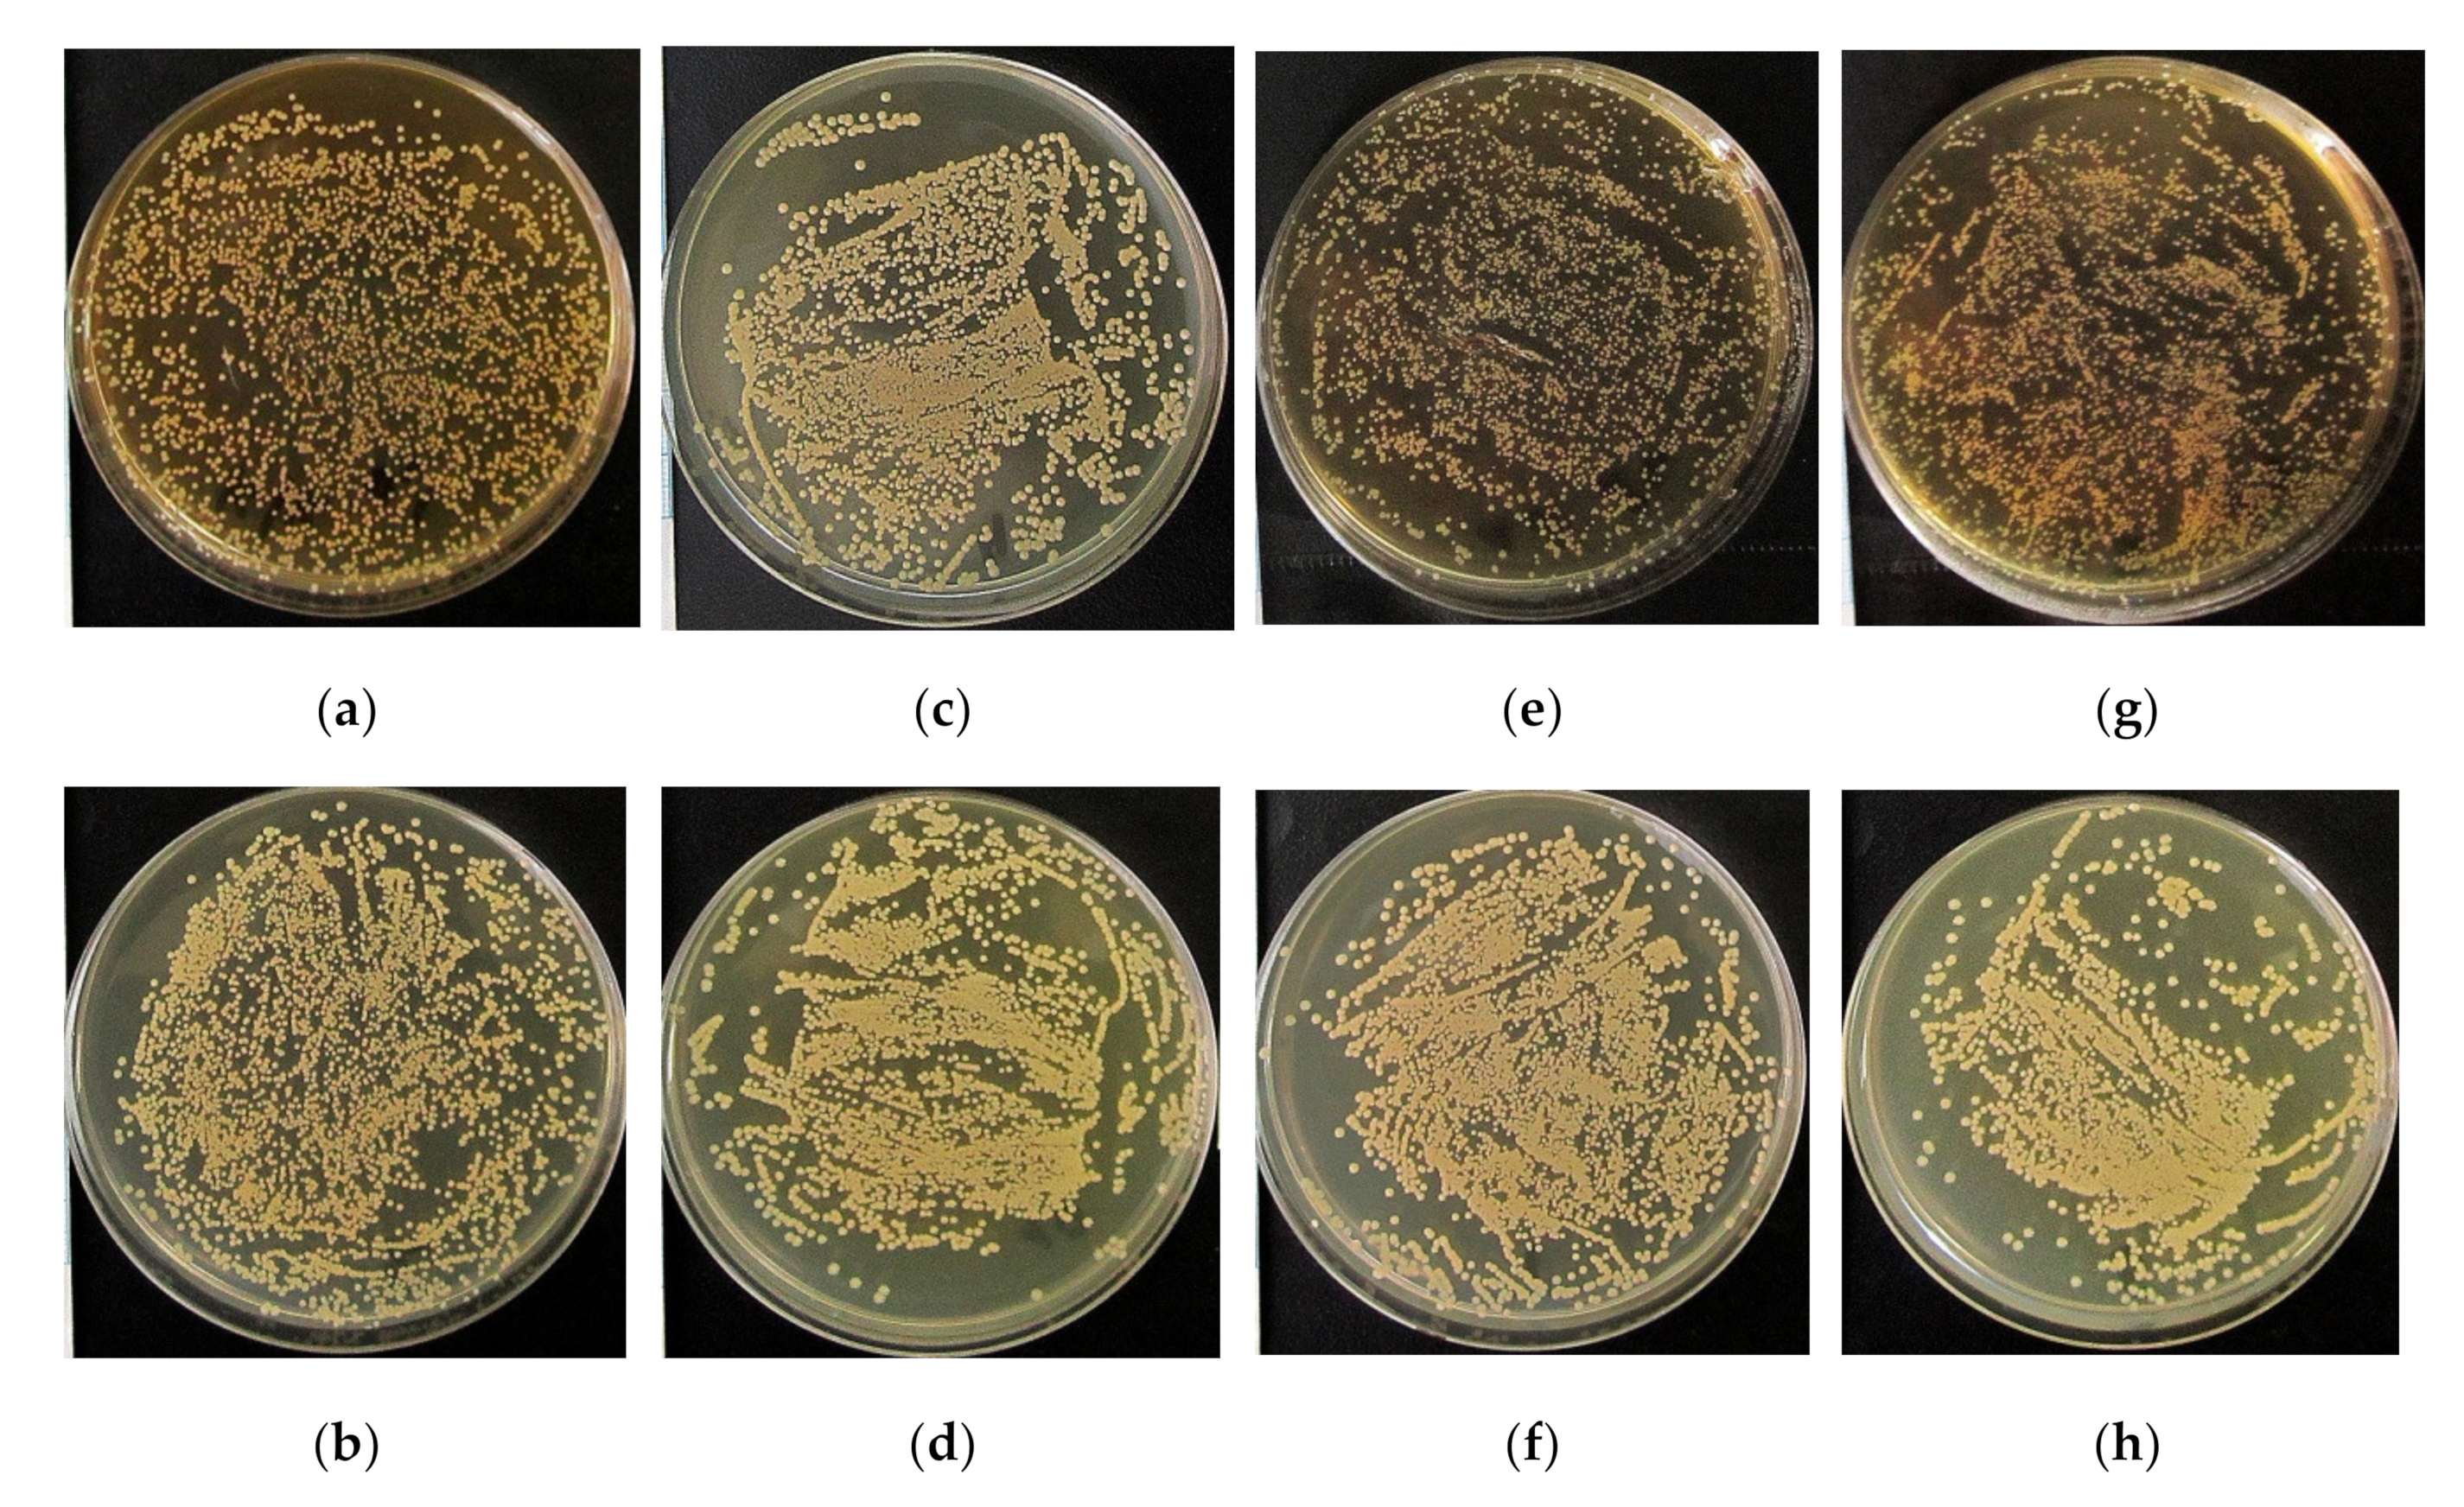
Materials 13 04366 g006 Materials 13 04366 g006

Zn- or Cu-containing CaP-Based Coatings Formed by Micro-Arc Oxidation on Titanium and Ti-40Nb Alloy: Part II—Wettability and Biological Performance
Abstract
1. Introduction
2. Materials and Methods
2.1. Materials and MAO Treatment
2.2. Wettability and Surface Energy Characterization
2.3. Biological Studies In Vitro
2.3.1. Cell-IQ In Vitro Visualization of Cell Morphology and Motility
2.3.2. Osteocalcin and Ion Concentration Estimation In Vitro
2.4. Antibacterial Test In Vitro
2.5. Ectopic Osteogenesis Test in Mice
2.6. Statistical Analysis
3. Results and Discussion
3.1. Wettability and Free Surface Energy
3.2. Biological Performance In Vitro
3.2.1. Multilineage Nature of hAMMSC Culture
3.2.2. hAMMSC Morphology and Motility
3.2.3. Osteocalcin and Ion Concentrations in Supernatants
3.3. Antibacterial Efficacy In Vitro
3.4. Ectopic Osteogenesis in Mice
4. Conclusions
Author Contributions
Funding
Acknowledgments
Conflicts of Interest
References
- Liu, X.; Chu, P.K.; Ding, C. Surface modification of titanium, titanium alloys, and related materials for biomedical applications. Mater. Sci. Eng. R Rep. 2004, 47, 49–121. [Google Scholar] [CrossRef]
- Li, Y.; Yang, C.; Zhao, H.; Qu, S.; Li, X.; Li, Y. New developments of Ti-based alloys for biomedical applications. Materials 2014, 7, 1709–1800. [Google Scholar] [CrossRef] [PubMed]
- Liu, W.; Cheng, M.; Wahafu, T.; Zhao, Y.; Qin, H.; Wang, J.; Zhang, X.; Wang, L. The in vitro and in vivo performance of a strontium-containing coating on the low-modulus Ti35Nb2Ta3Zr alloy formed by micro-arc oxidation. J. Mater. Sci. Mater. Med. 2015, 26, 203. [Google Scholar] [CrossRef] [PubMed]
- Mohammed, M.T.; Khan, Z.A.; Siddiquee, A.N. Beta titanium alloys: The lowest elastic modulus for biomedical applications: A review. Int. J. Chem. Nucl. Mater. Metall. Eng. 2014, 8, 822–827. [Google Scholar]
- Mohammed, M.T. Development of a new metastable beta titanium alloy for biomedical applications. Karbala Int. J. Mod. Sci. 2017, 3, 224–230. [Google Scholar] [CrossRef]
- Kaur, M.; Singh, K. Review on titanium and titanium based alloys as biomaterials for orthopaedic applications. Mater. Sci. Eng. C 2019, 102, 844–862. [Google Scholar] [CrossRef] [PubMed]
- Zhuravleva, K.; Chivu, A.; Teresiak, A.; Scudino, S.; Calin, M.; Schultz, L.; Eckert, J.; Gebert, A. Porous low modulus Ti40Nb compacts with electrodeposited hydroxyapatite coating for biomedical applications. Mater. Sci. Eng. C 2013, 33, 2280–2287. [Google Scholar] [CrossRef] [PubMed]
- Han, M.K.; Kim, J.Y.; Hwang, M.J.; Song, H.J.; Park, Y.J. Effect of Nb on the microstructure, mechanical properties, corrosion behavior, and cytotoxicity of Ti-Nb alloys. Materials 2015, 8, 5986–6003. [Google Scholar] [CrossRef]
- Elmay, W.; Prima, F.; Gloriant, T.; Bolle, B.; Zhong, Y.; Patoor, E.; Laheurte, P. Effects of thermomechanical process on the microstructure and mechanical properties of a fully martensitic titanium-based biomedical alloy. J. Mech. Behav. Biomed. Mater. 2013, 18, 47–56. [Google Scholar] [CrossRef]
- Karre, R.; Niranjan, M.K.; Dey, S.R. First principles theoretical investigations of low Young’s modulus beta Ti–Nb and Ti–Nb–Zr alloys compositions for biomedical applications. Mater. Sci. Eng. C 2015, 50, 52–58. [Google Scholar] [CrossRef]
- Marker, C.; Shang, S.L.; Zhao, J.C.; Liu, Z.K. Effects of alloying elements on the elastic properties of bcc Ti-X alloys from first-principles calculations. Comput. Mater. Sci. 2018, 142, 215–226. [Google Scholar] [CrossRef]
- Kovalevskaya, Z.G.; Khimich, M.A.; Belyakov, A.V.; Shulepov, I.A. Evaluation of physical and mechanical properties of structural components of Ti-Nb alloy. Adv. Mater. Res. 2014, 1040, 39–42. [Google Scholar] [CrossRef]
- Kovalevskaya, Z.G.; Khimich, M.A.; Belyakov, A.V.; Shulepov, I.A. Influence of severe plastic deformation on physicomechanical properties of Ti-40 mas% Nb alloy. In Key Engineering Materials; Trans Tech Publications Ltd.: Freienbach, Switzerland, 2016; Volume 685, pp. 525–529. [Google Scholar] [CrossRef]
- Chung, C.J.; Su, R.T.; Chu, H.J.; Chen, H.T.; Tsou, H.K.; He, J.L. Plasma electrolytic oxidation of titanium and improvement in osseointegration. J. Biomed. Mater. Res. Part B Appl. Biomater. 2013, 101B, 1023–1030. [Google Scholar] [CrossRef] [PubMed]
- Zhao, L.; Dang, Y.; Zhang, L.; Song, W.; Chang, B.; Han, T.; Zhang, Y. In vivo osseointegration of Ti implants with a strontium-containing nanotubular coating. Int. J. Nanomed. 2016, 11, 1003–1011. [Google Scholar] [CrossRef] [PubMed]
- Chung, C.J.; Long, H.Y. Systematic strontium substitution in hydroxyapatite coatings on titanium via micro-arc treatment and their osteoblast/osteoclast responses. Acta Biomater. 2011, 7, 4081–4087. [Google Scholar] [CrossRef] [PubMed]
- Huang, Y.; Wang, W.; Zhang, X.; Liu, X.; Xu, Z.; Han, S.; Su, Z.; Liu, H.; Gao, Y.; Yang, H. A prospective material for orthopedic applications: Ti substrates coated with a composite coating of a titania-nanotubes layer and a silver-manganese-doped hydroxyapatite layer. Ceram. Int. 2018, 44, 5528–5542. [Google Scholar] [CrossRef]
- Geng, Z.; Wang, R.; Zhuo, X.; Li, Z.; Huang, Y.; Ma, L.; Cui, Z.; Zhu, S.; Liang, Y.; Liu, Y.; et al. Incorporation of silver and strontium in hydroxyapatite coating on titanium surface for enhanced antibacterial and biological properties. Mater. Sci. Eng. C 2017, 71, 852–861. [Google Scholar] [CrossRef]
- Furko, M.; Jiang, Y.; Wilkins, T.; Balázsi, C. Development and characterization of silver and zinc doped bioceramic layer on metallic implant materials for orthopedic application. Ceram. Int. 2016, 42, 4924–4931. [Google Scholar] [CrossRef]
- Hu, H.; Zhang, W.; Qiao, Y.; Jiang, X.; Liu, X.; Ding, C. Antibacterial activity and increased bone marrow stem cell functions of Zn-incorporated TiO2 coatings on titanium. Acta Biomater. 2012, 8, 904–915. [Google Scholar] [CrossRef]
- Rizwan, M.; Alias, R.; Zaidi, U.Z.; Mahmoodian, R.; Hamdi, M. Surface modification of valve metals using plasma electrolytic oxidation for antibacterial applications: A review. J. Biomed. Mater. Res. Part A 2018, 106, 590–605. [Google Scholar] [CrossRef]
- Simchi, A.; Tamjid, E.; Pishbin, F.; Boccaccini, A.R. Recent progress in inorganic and composite coatings with bactericidal capability for orthopaedic applications. Nanomed. Nanotechnol. Biol. Med. 2011, 7, 22–39. [Google Scholar] [CrossRef] [PubMed]
- Campoccia, D.; Montanaro, L.; Arciola, C.R. A review of the biomaterials technologies for infection-resistant surfaces. Biomaterials 2013, 34, 8533–8554. [Google Scholar] [CrossRef] [PubMed]
- Gallo, J.; Holinka, M.; Moucha, C. Antibacterial surface treatment for orthopaedic implants. Int. J. Mol. Sci. 2014, 15, 13849–13880. [Google Scholar] [CrossRef] [PubMed]
- Karlov, A.V.; Khlusov, I.A.; Pontak, V.A.; Ignatov, V.P.; Ivin, M.A.; Zinatulina, S.Y. Adhesion of Staphylococcus aureus to implants with different physicochemical characteristics. Bull. Exp. Biol. Med. 2002, 134, 277–280. [Google Scholar] [CrossRef]
- Wu, Q.; Li, J.; Zhang, W.; Qian, H.; She, W.; Pan, H.; Wen, J.; Zhang, X.; Liu, X.; Jiang, X. Antibacterial property, angiogenic and osteogenic activity of Cu-incorporated TiO2 coating. J. Mater. Chem. B 2014, 2, 6738–6748. [Google Scholar] [CrossRef]
- Huang, Y.; Zhang, X.; Zhao, R.; Mao, H.; Yan, Y.; Pang, X. Antibacterial efficacy, corrosion resistance, and cytotoxicity studies of copper-substituted carbonated hydroxyapatite coating on titanium substrate. J. Mater. Sci. 2015, 50, 1688–1700. [Google Scholar] [CrossRef]
- Wang, X.; Ito, A.; Sogo, Y.; Li, X.; Oyane, A. Zinc-containing apatite layers on external fixation rods promoting cell activity. Acta Biomater. 2010, 6, 962–968. [Google Scholar] [CrossRef]
- Zhang, Z.; Gu, B.; Zhang, W.; Kan, G.; Sun, J. The enhanced characteristics of osteoblast adhesion to porous zinc–TiO2 coating prepared by plasma electrolytic oxidation. Appl. Surf. Sci. 2012, 258, 6504–6511. [Google Scholar] [CrossRef]
- Tite, T.; Popa, A.C.; Balescu, L.; Bogdan, I.; Pasuk, I.; Ferreira, J.; Stan, G. Cationic substitutions in hydroxyapatite: Current status of the derived biofunctional effects and their in vitro interrogation methods. Materials 2018, 11, 2081. [Google Scholar] [CrossRef]
- Wang, W.; Yeung, K.W.K. Bone grafts and biomaterials substitutes for bone defect repair: A review. Bioact. Mater. 2017, 2, 224–247. [Google Scholar] [CrossRef]
- Shi, F.; Liu, Y.; Zhi, W.; Xiao, D.; Li, H.; Duan, K.; Qu, S.; Weng, J. The synergistic effect of micro/nano-structured and Cu2+-doped hydroxyapatite particles to promote osteoblast viability and antibacterial activity. Biomed. Mater. 2017, 12, 035006. [Google Scholar] [CrossRef] [PubMed]
- Sedelnikova, M.B.; Komarova, E.G.; Sharkeev, Y.P.; Ugodchikova, A.V.; Mushtovatova, L.S.; Karpova, M.R.; Sheikin, V.V.; Litvinova, L.S.; Khlusov, I.A. Zn-, Cu- or Ag-incorporated micro-arc coatings on titanium alloys: Properties and behavior in synthetic biological media. Surf. Coat. Technol. 2019, 369, 52–68. [Google Scholar] [CrossRef]
- Komarova, E.G.; Sharkeev, Y.P.; Sedelnikova, M.B.; Khlusov, I.A.; Prymak, O.; Epple, M. Zn- or Cu-containing CaP-based coatings formed by micro-arc oxidation on titanium and Ti-40Nb alloy: Part I—Microstructure, composition and properties. Materials 2020, 13, 4116. [Google Scholar] [CrossRef] [PubMed]
- Youssef, W.; Wickett, R.R.; Hoath, S.B. Surface free energy characterization of vernix caseosa. Potential role in waterproofing the newborn infant. Skin Res. Technol. 2001, 7, 10–17. [Google Scholar] [CrossRef]
- Zuk, P.A.; Zhu, M.; Mizuno, H.; Huang, J.; Futrell, J.W.; Katz, A.J.; Benhaim, P.; Lorenz, H.P.; Hedrick, M.H. Multilineage cells from numan adipose tissue: Implications for cell-based therapies. Tissue Eng. 2001, 7, 211–228. [Google Scholar] [CrossRef]
- Khlusov, I.; Dekhtyar, Y.; Sharkeev, Y.; Pichugin, V.; Khlusova, M.; Polyaka, N.; Tyulkin, F.; Vendinya, V.; Legostaeva, E.; Litvinova, L.; et al. Nanoscale electrical potential and roughness of a calcium phosphate surface promotes the osteogenic phenotype of stromal cells. Materials 2018, 11, 978. [Google Scholar] [CrossRef]
- Dominici, M.; Le Blanc, K.; Mueller, I.; Slaper-Cortenbach, I.; Marini, F.C.; Krause, D.S.; Deans, R.J.; Keating, A.; Prockop, D.J.; Horwitz, E.M. Minimal criteria for defining multipotent mesenchymal stromal cells. The International Society for Cellular Therapy position statement. Cytotherapy 2006, 8, 315–317. [Google Scholar] [CrossRef]
- Bourin, P.; Bunnell, B.A.; Casteilla, L.; Dominici, M.; Katz, A.J.; March, K.L.; Redl, H.; Rubin, J.P.; Yoshimura, K.; Gimble, J.M. Stromal cells from the adipose tissue-derived stromal vascular fraction and culture expanded adipose tissue-derived stromal/stem cells: A joint statement of the International Federation for Adipose Therapeutics and Science (IFATS) and the International Society for Cellular Therapy (ISCT). Cytotherapy 2013, 15, 641–648. [Google Scholar] [CrossRef]
- Litvinova, L.S.; Shupletsova, V.V.; Yurova, K.A.; Khaziakhmatova, O.G.; Todosenko, N.M.; Khlusova, M.Y.; Slepchenko, G.B.; Cherempey, E.G.; Sharkeev, Y.P.; Komarova, E.G.; et al. Cell-IQ visualization of motility, cell mass, and osteogenic differentiation of multipotent mesenchymal stromal cells cultured with relief calcium phosphate coating. Dokl. Biochem. Biophys. 2017, 476, 310–315. [Google Scholar] [CrossRef]
- Garber, J.C.; Barbee, R.W.; Bielitzki, J.T.; Clayton, L.A.; Donovan, J.C.; Kohn, D.F.; Lipman, N.S.; Locke, P.A.; Melcher, J.; Quimby, F.W.; et al. Guide for the Care and Use of Laboratory Animals, 8th ed.; National Academies Press: Washington, WA, USA, 2011. [Google Scholar] [CrossRef]
- Bolbasov, E.N.; Popkov, A.V.; Popkov, D.A.; Gorbach, E.N.; Khlusov, I.A.; Golovkin, A.S.; Sinev, A.; Bouznik, V.M.; Tverdokhlebov, S.I.; Anissimov, Y.G. Osteoinductive composite coatings for flexible intramedullary nails. Mater. Sci. Eng. C 2017, 75, 207–220. [Google Scholar] [CrossRef]
- Aerts, F.; Wagemaker, G. Mesenchymal stem cell engineering and transplantation introduction. In Genetic Engineering of Mesenchymal Stem Cells; Nolta, J.A., Ed.; Springer: Dordrecht, The Netherlands, 2006; pp. 1–44. [Google Scholar] [CrossRef]
- Rupp, F.; Liang, L.; Geis-Gerstorfer, J.; Scheideler, L.; Hüttig, F. Surface characteristics of dental implants: A review. Dent. Mater. 2018, 34, 40–57. [Google Scholar] [CrossRef] [PubMed]
- Bodhak, S.; Bose, S.; Bandyopadhyay, A. Role of surface charge and wettability on early stage mineralization and bone cell–materials interactions of polarized hydroxyapatite. Acta Biomater. 2009, 5, 2178–2188. [Google Scholar] [CrossRef] [PubMed]
- Park, J.W.; Jang, J.H.; Lee, C.S.; Hanawa, T. Osteoconductivity of hydrophilic microstructured titanium implants with phosphate ion chemistry. Acta Biomater. 2009, 5, 2311–2321. [Google Scholar] [CrossRef] [PubMed]
- Rupp, F.; Scheideler, L.; Olshanska, N.; de Wild, M.; Wieland, M.; Geis-Gerstorfer, J. Enhancing surface free energy and hydrophilicity through chemical modification of microstructured titanium implant surfaces. J. Biomed. Mater. Res. Part A 2006, 76A, 323–334. [Google Scholar] [CrossRef]
- Yamamoto, H.; Shibata, Y.; Miyazaki, T. Anode glow discharge plasma treatment of titanium plates facilitates adsorption of extracellular matrix proteins to the plates. J. Dent. Res. 2005, 84, 668–671. [Google Scholar] [CrossRef]
- Bacakova, L.; Filova, E.; Parizek, M.; Ruml, T.; Svorcik, V. Modulation of cell adhesion, proliferation and differentiation on materials designed for body implants. Biotechnol. Adv. 2011, 29, 739–767. [Google Scholar] [CrossRef]
- Harnett, E.M.; Alderman, J.; Wood, T. The surface energy of various biomaterials coated with adhesion molecules used in cell culture. Colloids Surf. B Biointerfaces 2007, 55, 90–97. [Google Scholar] [CrossRef]
- Webb, K.; Hlady, V.; Tresco, P.A. Relative importance of surface wettability and charged functional groups on NIH 3T3 fibroblast attachment, spreading, and cytoskeletal organization. J. Biomed. Mater. Res. 1998, 41, 422–430. [Google Scholar] [CrossRef]
- Curtis, A.; Wilkinson, C. Topographical control of cells. Biomaterials 1997, 18, 1573–1583. [Google Scholar] [CrossRef]
- Anselme, K. Osteoblast adhesion on biomaterials. Biomaterials 2000, 21, 667–681. [Google Scholar] [CrossRef]
- Pešáková, V.; Kubies, D.; Hulejová, H.; Himmlová, L. The influence of implant surface properties on cell adhesion and proliferation. J. Mater. Sci. Mater. Med. 2007, 18, 465–473. [Google Scholar] [CrossRef] [PubMed]
- Yamaguchi, M.; Goto, M.; Uchiyama, S.; Nakagawa, T. Effect of zinc on gene expression in osteoblastic MC3T3-E1 cells: Enhancement of Runx2, OPG, and regucalcin mRNA expressions. Mol. Cell. Biochem. 2008, 312, 157–166. [Google Scholar] [CrossRef] [PubMed]
- Pablo Rodrguez, J.; Ros, S.; Gonzlez, M. Modulation of the proliferation and differentiation of human mesenchymal stem cells by copper. J. Cell. Biochem. 2002, 85, 92–100. [Google Scholar] [CrossRef] [PubMed]
- Khlusov, I.A.; Khlusova, M.Y.; Zaitsev, K.V.; Kolokol’tsova, T.D.; Sharkeev, Y.P.; Pichugin, V.F.; Legostaeva, E.V.; Trofimova, I.E.; Klimov, A.S.; Zhdanova, A.I. Pilot in vitro study of the parameters of artificial niche for osteogenic differentiation of human stromal stem cell pool. Bull. Exp. Biol. Med. 2011, 150, 535–542. [Google Scholar] [CrossRef] [PubMed]
- Riggs, B.L.; Melton, L.J., III. Osteoporosis: Etiology, Diagnosis, and Management, 2nd ed.; Lippincott-Raven: Philadelphia, PA, USA, 1995; p. 524. [Google Scholar]
- Sharkeev, Y.; Komarova, E.; Sedelnikova, M.; Khlusov, I.A.; Eroshenko, A.; Litvinova, L.; Shupletsova, V. Bioactive micro-arc calcium phosphate coatings on nanostructured and ultrafine-grained bioinert metals and alloys. In Bioceramics and Biocomposites; Antoniac, I., Ed.; John Wiley & Sons: New Jersey, NJ, USA, 2019; pp. 191–231. [Google Scholar] [CrossRef]
- Coleman, J.E. Structure and mechanism of alkaline phosphatase. Annu. Rev. Biophys. Biomol. Struct. 1992, 21, 441–483. [Google Scholar] [CrossRef] [PubMed]
- Hall, S.L.; Dimai, H.P.; Farley, J.R. Effects of zinc on human skeletal alkaline phosphatase activity in vitro. Calcif. Tissue Int. 1999, 64, 163–172. [Google Scholar] [CrossRef] [PubMed]
- Khlusov, I.A.; Karlov, A.V.; Sharkeev, Y.P.; Pichugin, V.F.; Kolobov, Y.P.; Shashkina, G.A.; Ivanov, M.B.; Legostaeva, E.V.; Sukhikh, G.T. Osteogenic potential of mesenchymal stem cells from bone marrow in situ: Role of physicochemical properties of artificial surfaces. Bull. Exp. Biol. Med. 2005, 140, 144–152. [Google Scholar] [CrossRef]
- Albrektsson, T.; Johansson, C. Osteoinduction, osteoconduction and osseointegration. Eur. Spine J. 2001, 10, S96–S101. [Google Scholar] [CrossRef]
- Bayer, E.A.; Gottardi, R.; Fedorchak, M.V.; Little, S.R. The scope and sequence of growth factor delivery for vascularized bone tissue regeneration. J. Control. Release 2015, 219, 129–140. [Google Scholar] [CrossRef]
- Parvizi, J.; Gehrke, T.; Chen, A.F. Proceedings of the international consensus on periprosthetic joint infection. Bone Jt. J. 2003, 95B, 1450–1452. [Google Scholar] [CrossRef]
- Nepola, J.V. External fixation. In Rockwood and Green’s Fractures in Adults, 4th ed.; Rockwood, C.A., Jr., Green, D.P., Eds.; Lippincott Raven: Philadelphia, PA, USA, 1996; pp. 229–304. [Google Scholar]
- Taylor, D. Bone maintenance and remodeling: A control system based on fatigue damage. J. Orthop. Res. 1997, 15, 601–606. [Google Scholar] [CrossRef] [PubMed]
- Gamie, Z.; Tran, G.T.; Vyzas, G.; Korres, N.; Heliotis, M.; Mantalaris, A.; Tsiridis, E. Stem cells combined with bone graft substitutes in skeletal tissue engineering. Expert Opin. Biol. Ther. 2012, 12, 713–729. [Google Scholar] [CrossRef] [PubMed]
- Im, G.I.; Shin, Y.W.; Lee, K.B. Do adipose tissue-derived mesenchymal stem cells have the same osteogenic and chondrogenic potential as bone marrow-derived cells? Osteoarthr. Cartil. 2005, 13, 845–853. [Google Scholar] [CrossRef] [PubMed]
- Scott, M.A.; Levi, B.; Askarinam, A.; Nguyen, A.; Rackohn, T.; Kang, T.; Chia, S.; James, A.W. Brief review of models of ectopic bone formation. Stem Cells Dev. 2012, 21, 655–667. [Google Scholar] [CrossRef]
- Miron, R.J.; Zhang, Y.F. Osteoinduction: A review of old concepts with new standards. J. Dent. Res. 2012, 91, 736–744. [Google Scholar] [CrossRef]
- Chan, C.K.F.; Chen, C.C.; Luppen, C.A.; Kim, J.B.; DeBoer, A.T.; Wei, K.; Helms, J.A.; Kuo, C.J.; Kraft, D.L.; Weissman, I.L. Endochondral ossification is required for haematopoietic stem-cell niche formation. Nature 2009, 457, 490–494. [Google Scholar] [CrossRef]
- Włodarski, K.H.; Reddi, A.H. Importance of skeletal muscle environment for ectopic bone induction in mice. Folia Biol. 1986, 34, 425–434. [Google Scholar]
- Kawamura, H.; Ito, A.; Miyakawa, S.; Layrolle, P.; Ojima, K.; Ichinose, N.; Tateishi, T. Stimulatory effect of zinc-releasing calcium phosphate implant on bone formation in rabbit femora. J. Biomed. Mater. Res. 2000, 50, 184–190. [Google Scholar] [CrossRef]

| Type of the Coating | Voltage, V | Coating Roughness [34], µm | Coating Porosity [34], % | Water Contact Angle, ° | Glycerol Contact Angle, ° | Polar Component, mJ/m2 | Dispersive Component, mJ/m2 | Free Surface Energy, mJ/m2 | ||
|---|---|---|---|---|---|---|---|---|---|---|
| Ti substrate | ||||||||||
| CaP | 200 | 2.9 ± 0.5 | 16.2 ± 0.8 | 16.2 ± 1.5 | ![]() | 30.0 ± 0.6 | ![]() | 67.3 ± 0.4 | 7.3 ± 0.2 | 74.6 ± 0.5 |
| Zn-CaP | 3.2 ± 0.2 | 17.7 ± 0.6 | 22.1 ± 1.9 | 36.4 ± 1.8 | 69.9 ± 0.4 | 5.6 ± 0.1 | 75.5 ± 0.5 | |||
| Cu-CaP | 3.0 ± 0.2 | 17.8 ± 0.2 | 19.0 ± 1.9 | 34.2 ± 1.4 | 69.6 ± 0.8 | 5.2 ± 0.2 | 74.4 ± 1.0 | |||
| CaP | 250 | 4.0 ± 0.4 | 19.1 ± 0.7 | 13.2 ± 1.1 | ![]() | 25.0 ± 0.8 | ![]() | 63.2 ± 0.4 | 10.9 ± 0.3 | 74.1 ± 0.8 |
| Zn-CaP | 4.5 ± 0.2 | 21.2 ± 0.6 | 18.0 ± 1.8 | 30.4 ± 1.5 | 64.6 ± 0.5 | 8.5 ± 0.2 | 73.1 ± 0.7 | |||
| Cu-CaP | 4.4 ± 0.4 | 21.6 ± 0.4 | 17.0 ± 1.8 | 28.3 ± 1.3 | 67.2 ± 0.7 | 7.3 ± 0.2 | 74.5 ± 0.9 | |||
| CaP | 300 | 5.0 ± 0.5 | 21.4 ± 0.9 | 10.5 ± 0.8 | ![]() | 20.5 ± 0.6 | ![]() | 61.1 ± 1.0 | 11.3 ± 0.6 | 73.4 ± 1.6 |
| Zn-CaP | 5.9 ± 0.3 | 24.4 ± 0.7 | 14.7 ± 0.7 | 24.4 ± 1.2 | 61.1 ± 0.4 | 11.3 ± 0.3 | 72.3 ± 0.7 | |||
| Cu-CaP | 5.9 ± 0.2 | 24.1 ± 0.2 | 12.6 ± 0.7 | 23.3 ± 1.1 | 64.3 ± 0.3 | 8.6 ± 0.1 | 72.9 ± 0.4 | |||
| CaP | 350 | 6.3 ± 0.4 | 24.1 ± 1.2 | 6.3 ± 0.8 | ![]() | 17.0 ± 0.5 | ![]() | 57.9 ± 0.5 | 12.5 ± 0.3 | 72.7 ± 0.6 |
| Zn-CaP | 7.2 ± 0.6 | 25.0 ± 1.8 | 10.3 ± 0.9 | 18.2 ± 0.8 | 59.9 ± 0.6 | 12.7 ± 0.4 | 72.6 ± 0.6 | |||
| Cu-CaP | 7.2 ± 0.4 | 25.2 ± 0.4 | 9.8 ± 0.7 | 17.7 ± 0.7 | 60.6 ± 0.5 | 12.3 ± 0.3 | 72.9 ± 0.7 | |||
| Ti-40Nb substrate | ||||||||||
| CaP | 200 | 3.2 ± 0.3 | 15.7 ± 0.5 | 16.2 ± 1.6 | ![]() | 33.2 ± 2.6 | ![]() | 69.5 ± 0.4 | 6.5 ± 0.1 | 76.0 ± 0.5 |
| Zn-CaP | 3.3 ± 0.5 | 16.7 ± 0.5 | 20.6 ± 1.5 | 42.3 ± 2.9 | 75.3 ± 0.7 | 3.3 ± 0.1 | 78.6 ± 0.9 | |||
| Cu-CaP | 3.3 ± 0.4 | 16.7 ± 0.5 | 19.4 ± 1.8 | 39.8 ± 2.7 | 79.0 ± 1.0 | 2.4 ± 0.2 | 81.4 ± 1.2 | |||
| CaP | 250 | 4.7 ± 0.3 | 17.6 ± 0.6 | 14.2 ± 1.3 | ![]() | 28.7 ± 1.9 | ![]() | 66.1 ± 0.4 | 8.5 ± 0.2 | 74.6 ± 0.6 |
| Zn-CaP | 4.8 ± 0.2 | 19.9 ± 0.8 | 18.0 ± 1.8 | 37.6 ± 2.2 | 70.6 ± 0.5 | 5.8 ± 0.2 | 76.4 ± 0.7 | |||
| Cu-CaP | 4.9 ± 0.4 | 19.6 ± 0.6 | 16.9 ± 1.3 | 34.6 ± 2.1 | 75.0 ± 0.4 | 3.9 ± 0.1 | 78.9 ± 0.5 | |||
| CaP | 300 | 6.0 ± 0.2 | 21.0 ± 0.6 | 10.5 ± 0.8 | ![]() | 25.0 ± 1.8 | ![]() | 64.2 ± 0.3 | 10.0 ± 0.1 | 74.2 ± 0.5 |
| Zn-CaP | 6.9 ± 0.5 | 22.9 ± 1.1 | 13.7 ± 0.9 | 27.4 ± 1.9 | 63.1 ± 0.3 | 10.1 ± 0.2 | 74.0 ± 0.4 | |||
| Cu-CaP | 7.1 ± 0.2 | 23.0 ± 0.9 | 12.5 ± 0.9 | 26.1 ± 1.8 | 64.2 ± 0.3 | 9.9 ± 0.1 | 74.1 ± 0.5 | |||
| Stromal Cell Markers, % | Hematopoietic Cell Markers, % | ||
|---|---|---|---|
| CD73 | CD90 | CD105 | [CD45, 34, 20, 14] |
| 98.46 (98.36–98.95) | 98.57 (98.09–99.93) | 98.91 (98.43–99.05) | 1.34 (1.26–1.93) |
| No. | Groups, n = 3 | Coating Roughness [34], μm | Coating Mass, mg | Coating Thickness [34], µm | ALVFM of Cells, µm/h | Osteocalcin Concentration, ng/mL | [Ca2+], mM | [Ca] Total, mM | [PO43−], mM |
|---|---|---|---|---|---|---|---|---|---|
| 1. | Cells in sample-free DMEM (control), n = 6 | - | - | - | 35 ± 11 n1 = 21 | 1.64 (1.44–1.78) | 0.84 (0.83–0.85) | 2.43 (2.41–2.53) | 1.31 (1.28–1.41) |
| 2. | Cells in sample-free osteogenic medium | - | - | - | - | 3.22 * (2.82–5.48) p1 < 0.05 | - | - | - |
| Ti substrate | |||||||||
| 3. | CaP coating | 2.9 (2.4–3.3) | 13.5 (13.0–21.2) | 48.3 (45.6–54.5) | 33 ± 17n1 = 15 | 2.13 (2.07–2.47) | 0.81 * (0.80–0.82) p1 < 0.05 | 2.24 * (1.91–2.31) p1 < 0.05 | 1.20 (1.14–1.30) |
| 4. | Zn-CaP coating | 3.2 (3.0–3.4) | 14.9 (11.0–18.3) | 50.2 (47.5–58.2) | 42 ± 22 n1 = 10 | 2.13 (1.72–2.93) | 0.82 (0.82–0.83) | 2.17 * (2.01–2.18) p1 < 0.05 | 1.19 * (0.74–1.23) p1 < 0.05 |
| 5. | Cu-CaP coating | 3.0 (2.8–3.2) | 14.3 (14.0–19.7) | 54.2 (50.2–60.5) | 32 ± 19 n1 = 36 | 2.82 * (2.59–3.79) p1 < 0.05 | 0.83 (0.79–0.83) | 2.24 * (2.22–2.30) p1 < 0.05 | 1.29 (1.18–1.30) |
| Ti-40Nb substrate | |||||||||
| 6. | CaP coating | 3.2 (2.9–3.5) | 14.7 (13.8–18.4) | 56.5 (51.2–60.2) | 33 ± 10 n1 = 32 | 1.95 (1.72–2.41) | 0.84 (0.82–0.86) | 2.21 * (2.21–2.22) p1 < 0.05 | 1.27 * (1.18–1.30) p1 < 0.05 |
| 7. | Zn-CaP coating | 3.3 (2.8–3.8) | 15.0 (15.0–15.1) | 58.3 (54.5–61.5) | 41 ± 11 * n1 = 37 p6 < 0.02 | 2.30 (2.13–2.36) | 0.81 (0.81–0.82) | 2.24 (2.20–2.43) | 1.26 (1.24–1.34) |
| 8. | Cu-CaP coating | 3.3 (2.9–3.7) | 15.0 (15.0–15.2) | 60.0 (55.3–64.5) | 34 ± 11 n1 = 18 | 2.41 * (2.18–2.87) p1 < 0.05 | 0.82 (0.82–0.83) | 2.20 * (2.17–2.22) p1 < 0.05 | 1.26 (1.23–1.32) |
| No. | Groups, n = 3 | Relative area of S. aureus Colonies per Total Area of Petri Dish (%) | |
|---|---|---|---|
| Ti Substrate | Ti-40Nb Substrate | ||
| 1. | 0.9% NaCl (control 1) | 28 (27–29) | |
| 2. | RPMI-1640 (control 2) | 43 1 (41–45) | 42 1 (40–45) |
| 3. | CaP coating | 40 1 (40–44) | 45 1 (43–46) |
| 4. | Zn-CaP coating | 26 2,3 (25–27) | 35 1−3 (34–37) |
| 5. | Cu-CaP coating | 39 1−3 (38–39) | 34 1−3 (33–35) |
| Groups, n = 3 | Tissue lamellae Properties | ||
|---|---|---|---|
| Incidence of Tissue Lamellae, % | Incidence of Bone Formation, % | Histological Composition | |
| Ti substrate | |||
| CaP coating | 100 | 100 | Bone with marrow (Figure 8a); bone lamellae (Figure 8b). |
| Zn-CaP coating | 100 | 67 | Bone lamellae (Figure 8c); connective tissue ossification (Figure 8d); connective tissue (not shown). |
| Cu-CaP coating | 100 | 67 | Bone with marrow (Figure 8e); bone lamellae (Figure 8f); connective tissue (not shown). |
| Ti-40Nb substrate | |||
| CaP coating | 100 | 67 | Bone lamellae (Figure 9a); connective tissue ossification (Figure 9b); connective tissue (not shown). |
| Zn-CaP coating | 100 | 67 | Bone lamellae (Figure 9c); connective tissue ossification (Figure 9d); adipose, muscle and connective tissues (not shown). |
| Cu-CaP coating | 100 | 67 | Bone lamellae (Figure 9e); connective tissue ossification (Figure 9f); connective tissue (not shown). |
© 2020 by the authors. Licensee MDPI, Basel, Switzerland. This article is an open access article distributed under the terms and conditions of the Creative Commons Attribution (CC BY) license (http://creativecommons.org/licenses/by/4.0/).
Share and Cite
Komarova, E.G.; Sharkeev, Y.P.; Sedelnikova, M.B.; Prymak, O.; Epple, M.; Litvinova, L.S.; Shupletsova, V.V.; Malashchenko, V.V.; Yurova, K.A.; Dzyuman, A.N.; et al. Zn- or Cu-containing CaP-Based Coatings Formed by Micro-Arc Oxidation on Titanium and Ti-40Nb Alloy: Part II—Wettability and Biological Performance. Materials 2020, 13, 4366. https://doi.org/10.3390/ma13194366
Komarova EG, Sharkeev YP, Sedelnikova MB, Prymak O, Epple M, Litvinova LS, Shupletsova VV, Malashchenko VV, Yurova KA, Dzyuman AN, et al. Zn- or Cu-containing CaP-Based Coatings Formed by Micro-Arc Oxidation on Titanium and Ti-40Nb Alloy: Part II—Wettability and Biological Performance. Materials. 2020; 13(19):4366. https://doi.org/10.3390/ma13194366
Chicago/Turabian StyleKomarova, Ekaterina G., Yurii P. Sharkeev, Mariya B. Sedelnikova, Oleg Prymak, Matthias Epple, Larisa S. Litvinova, Valeria V. Shupletsova, Vladimir V. Malashchenko, Kristina A. Yurova, Anna N. Dzyuman, and et al. 2020. "Zn- or Cu-containing CaP-Based Coatings Formed by Micro-Arc Oxidation on Titanium and Ti-40Nb Alloy: Part II—Wettability and Biological Performance" Materials 13, no. 19: 4366. https://doi.org/10.3390/ma13194366
APA StyleKomarova, E. G., Sharkeev, Y. P., Sedelnikova, M. B., Prymak, O., Epple, M., Litvinova, L. S., Shupletsova, V. V., Malashchenko, V. V., Yurova, K. A., Dzyuman, A. N., Kulagina, I. V., Mushtovatova, L. S., Bochkareva, O. P., Karpova, M. R., & Khlusov, I. A. (2020). Zn- or Cu-containing CaP-Based Coatings Formed by Micro-Arc Oxidation on Titanium and Ti-40Nb Alloy: Part II—Wettability and Biological Performance. Materials, 13(19), 4366. https://doi.org/10.3390/ma13194366















